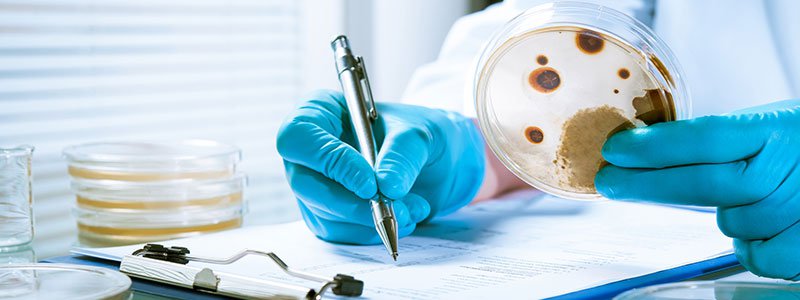

Summer Food Safety Quiz: Test Your Food Safety IQ (answer)
Answers FAQ
Summer Food Safety FAQs
Test your Knowledge!
- The refrigerator door is the best place to store eggs, milk, and meat. True or False?
- The transfer of harmful bacteria to other items, surfaces, or foods describes what?
- Should you wash meats before you cook them?
- For how long is raw ground beef safe in the refrigerator?
- A "sell by" date on a package is a guide. Food is good for up to 7 days after the "sell by" date. True or False?
- What is Listeria?
- Foodborne illness (food poisoning) is at its highest in the summer. True or False?
- Most people will get sick within hours of eating contaminated food. True or False?
- What is the main cause of food poisoning?
- The best way to tell if meat is thoroughly cooked is by what?
- What is the number one food safety mistake in the U.S?
- Is it ever safe to place cooked meat on a plate that held raw meat?
- It is not necessary to wash fruits or vegetables if you're going to peel them. True or False?
- While shopping for BBQ food items, what should be picked up right before checkout?
- Improve your Health I.Q. on Summer Food Safety
- Summer Food Safety Related Slideshows
- Summer Food Safety Related Image Collections

Q:The refrigerator door is the best place to store eggs, milk, and meat. True or False?
A:False. Eggs, milk, or meat should never be stored in the refrigerator door.
Why? The refrigerator door is subject to frequent fluctuations in temperature. The refrigerator door is best for storing condiments that will not spoil as easily as foods like eggs, milk, and meat.

Q:The transfer of harmful bacteria to other items, surfaces, or foods describes what?
A:The transfer of harmful bacteria to other items, surfaces, or foods describes cross-contamination. Cross-contamination is the transfer of harmful bacteria to food from other foods, cutting boards, utensils, etc., if they are not handled properly. This is especially true when handling raw meat, poultry, and seafood, so keep these foods and their juices away from already cooked or ready-to-eat foods and fresh produce.
Cross-contamination is dangerous because it can cause foodborne illness (food poisoning). Foodborne illness is a preventable public health challenge that causes an estimated 48 million illnesses and 3,000 deaths each year in the United States.

Q:Should you wash meats before you cook them?
A:No! You should NOT wash meats before cooking.
Washing raw poultry, beef, pork, lamb, or veal before cooking it is not recommended. Cooking (baking, broiling, boiling, and grilling) to the right temperature kills the bacteria, so washing meats is not necessary.
Why not wash meats before cooking them? There are a few reasons. First, some of the bacteria on meats and fish are so tightly attached that you could not remove them no matter how many times you washed the meat. Second, some bacteria can only be killed at temperatures that are far hotter than regular household water temperatures can reach. Lastly, there are other types of bacteria that can be easily washed off and splashed on the surfaces of the kitchen.

Q:For how long is raw ground beef safe in the refrigerator?
A:Raw ground beef in the refrigerator is safe for 1 to 2 days. Uncooked hamburger, ground beef, turkey, veal, pork, lamb, and mixtures of these meats are good for 1 to 2 days in the refrigerator. In the freezer, these foods will maintain their quality for 3 to 4 months.
Note: The 3- to 4-month range refers to quality only. Frozen foods remain safe indefinitely.

Q:A "sell by" date on a package is a guide. Food is good for up to 7 days after the "sell by" date. True or False?
A:False. You should not buy a product after the "sell by" date. A "sell-by" date tells the store how long to display the product for sale. You should buy the product before the date expires.
Other types of useful dates for food and food products are:
Best if Used By (or Before): This date is recommended for best flavor or quality. It is not a purchase or safety date.
Use-By: This date is the last date recommended for the use of the product while at peak quality. The date has been determined by the manufacturer of the product.
Closed or Coded Dates are packing numbers for use by the manufacturer.
Q:What is Listeria?
A:Ther term Listeria refers to a group of foodborne bacteria. Listeria, specifically Listeria monocytogenes, is a group of bacteria capable of causing illness including potentially fatal infections in the elderly, newborns, pregnant women, and persons with a weakened immune system. Listeria is a very common bacterium with an unusual trait: It can grow at refrigerator temperatures. And it can build up in food-processing plants, where it can survive for years.
Listeria contamination has been responsible for numerous recalls of food and may be spread through foodborne transmission. Persons at risk can prevent the infection by avoiding certain high-risk foods and by handling food properly. You should thoroughly cook raw food from animal sources (such as beef, pork, or poultry); keep uncooked meats separate from vegetables, cooked foods, and ready-to-eat foods; wash raw vegetables thoroughly before eating them, and avoid raw (unpasteurized) milk or foods made from raw milk.
Fun fact: Like the famous mouthwash Listerine, Listeria monocytogenes was named after antiseptic pioneer Joseph Lister.

Q:Foodborne illness (food poisoning) is at its highest in the summer. True or False?
A:True. Foodborne illnesses do increase during the summer, and the reasons appear to be twofold.
First, bacteria grow faster in the warm summer months. Most foodborne bacteria grow fastest at temperatures from 90° to 110° F (32.3° to 43.3° C). Bacteria also need moisture to flourish, and summer weather is often hot and humid.
Second, more people are cooking outdoors during summer months. The safety controls that a kitchen provides such as thermostat-controlled cooking, refrigeration, and washing facilities are usually not available.
According to the CDC data a foodborne pathogen called Campylobacter is the number one cause of foodborne disease in the United States.

Q:Most people will get sick within hours of eating contaminated food. True or False?
A:False. People rarely get sick from contaminated food, because most people have healthy immune systems that protect them from harmful bacteria or viruses on food and other harmful organisms in the environment.
When people are infected by foodborne bacteria or viruses, the onset of symptoms may occur within minutes to weeks and often presents itself as flu-like symptoms, as the ill person may experience symptoms such as nausea, vomiting, diarrhea, or fever. Because the symptoms are often flu-like, many people may not recognize that the illness is caused by harmful bacteria or other pathogens in food.

Q:What is the main cause of food poisoning?
A:Keeping food at an unsafe temperature is the prime cause of food poisoning. Consider these tips for summer food safety (and year-round):
- Cold, refrigerated perishable food like luncheon meats, cooked meats, chicken, and potato or pasta salads should be kept in an insulated cooler packed with several inches of ice or ice packs.
- Consider packing canned beverages in one cooler and perishable food in another cooler because the beverage cooler will probably be opened frequently.
- Keep the cooler in the coolest part of the car, and place in the shade or shelter, and out of the sun, whenever possible.
- Preserve the cold temperature of the cooler by replenishing the ice as soon as it starts melting.
- If a cooler chest is not an option, consider taking fruits, vegetables, hard cheeses, canned or dried meats, dried cereal, bread, peanut butter, crackers, and a bottle of refreshing beverage.
- Take-out food: If you don't plan to eat take-out food within 2 hours of purchase, plan ahead and chill the food in your refrigerator before packing for your outing.

Q:The best way to tell if meat is thoroughly cooked is by what?
A:The best way to tell if meat is thoroughly cooked is by using a thermometer to determine internal temperature. Meat and poultry cooked on a grill often brown very fast on the outside. Even the most expert griller can't tell when food is done just by looking at it -- or even cutting into it. A meat thermometer gives the best reading, so you won't be stuck with dried out, overcooked meats. You can take foods off the grill when they reach these internal temperatures:
- Poultry: 165° F
- Ground beef, pork, lamb, and veal: 160° F
- Beef, pork, lamb, and veal (steaks, roasts, and chops): 145° F

Q:What is the number one food safety mistake in the U.S?
A:Tasting food to determine if it's fit to eat is the number one dangerous food mistake in the U.S.
Why? Because you can't taste or smell or see the bacteria or viruses that cause food poisoning. Tasting only a tiny amount can cause serious illness. When it comes to some germs, such as Salmonella, all it takes is 15 to 20 cells in undercooked food to cause food poisoning. And just a tiny taste of food with botulism toxin can cause paralysis and even death.
As a general rule: When in doubt, throw it out.

Q:Is it ever safe to place cooked meat on a plate that held raw meat?
A:No, it is never safe to place cooked meat on a plate that held raw meat. This is the second worst food safety mistake in America.
Why isn't it safe? Placing cooked meat on a plate that held raw meat is a bad idea because germs from the raw meat can easily spread to the cooked meat. Always use separate plates for raw meat and cooked meat. The same rule applies to poultry and seafood.
Below is a list of the top 10 dangerous food safety mistakes in America:
Mistake #1: Tasting food to see if it's still fit to eat
Mistake #2: Putting cooked meat back on a plate that held raw meat
Mistake #3: Thawing food on the counter
Mistake #4: Washing meat or poultry
Mistake #5: Letting food cool before putting it in the fridge
Mistake #6: Eating raw cookie dough (or other foods with uncooked eggs)
Mistake #7: Marinating meat or seafood on the counter
Mistake #8: Using raw meat marinade on cooked food
Mistake #9: Undercooking meat, poultry, seafood, or eggs
Mistake #10: Not washing your hands

Q:It is not necessary to wash fruits or vegetables if you're going to peel them. True or False?
A:False. Because it's easy to transfer bacteria from the peel or rind you're cutting to the inside of your fruits and veggies, it's important to wash all produce, even if you plan to peel it.
Also, some people feel the need to use soap or detergent on fruits and vegetables before using them. In fact, it's best not to use soaps or detergents on produce, since these products can linger on foods and are not safe for consumption. Using clean running water is actually the best way to remove bacteria and wash produce safely.

Q:While shopping for BBQ food items, what should be picked up right before checkout?
A:Cold foods like meat and poultry should be obtained last, right before checkout. Separate raw meat and poultry from other food in your shopping cart. To guard against cross-contamination — which can happen when raw meat or poultry juices drip on other food — put packages of raw meat and poultry into plastic bags. Plan to drive directly home from the grocery store. You may want to take a cooler with ice for perishables. Always refrigerate perishable food within 2 hours. Refrigerate within 1 hour when the temperature is above 90 F (32.2 C).
&Copy; 1996-2022 MedicineNet, Inc. All rights reserved.Source quiz on MedicineNet
Improve your Health I.Q. on Summer Food Safety
- Learn More About
Food Poisoning - View the Food Poisoning Slideshow

